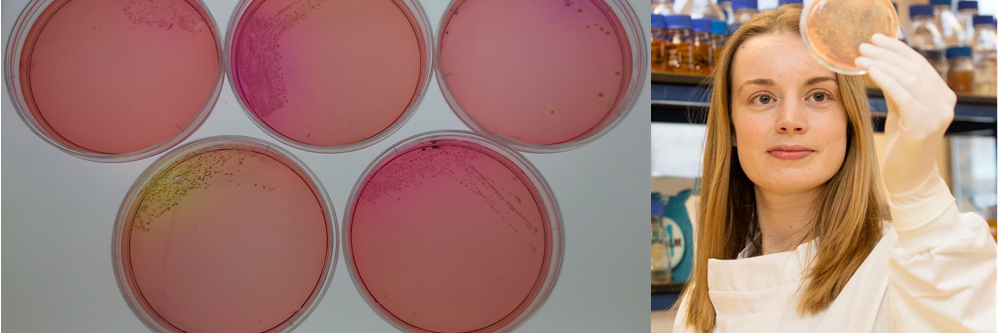
Geoghegan Lab banner

Huge congratulations to Professor Lindsay Hall @hall_lab, who has been named as one of the UK’s 2025 Goalkeepers by @WIRED Consulting and The @gatesfoundation. Lindsay sits alongside other visionaries of global development, taking on the world’s biggest problems.